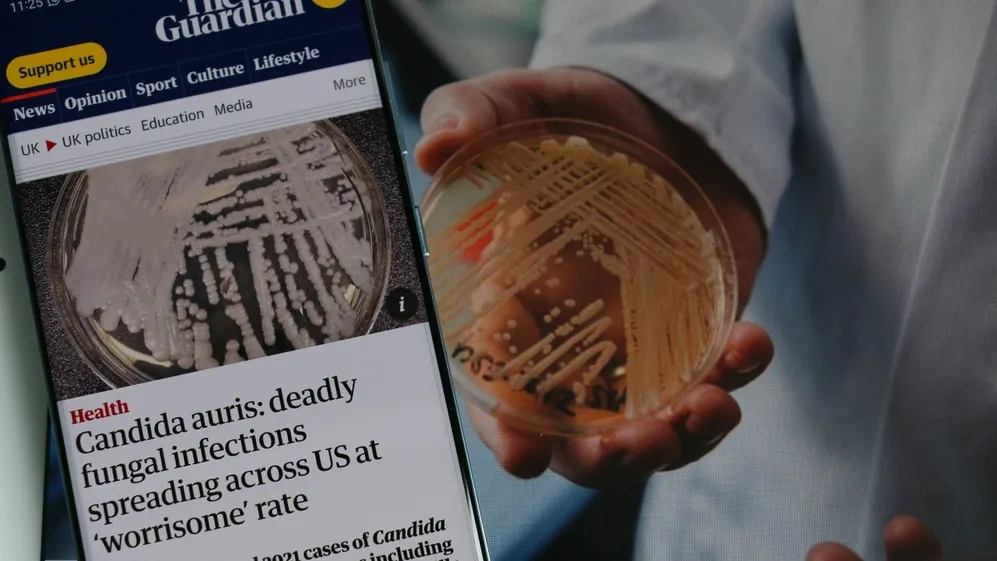
pic

Птичий грипп уже не только птичий: ученый предупредил об угрозе H5N1
Вирус H5N1 (клады 2.3.4.4b), ранее считавшийся птичьим, адаптировался к млекопитающим и начал эффективно размножаться при температуре человеческого тела, сообщил Тасс заведующий кафедрой инфекционных болезней и эпидемиологии Института клинической медицины Пироговского университета Минздрава России, доктор медицинских наук, профессор Мурад Шахмарданов.